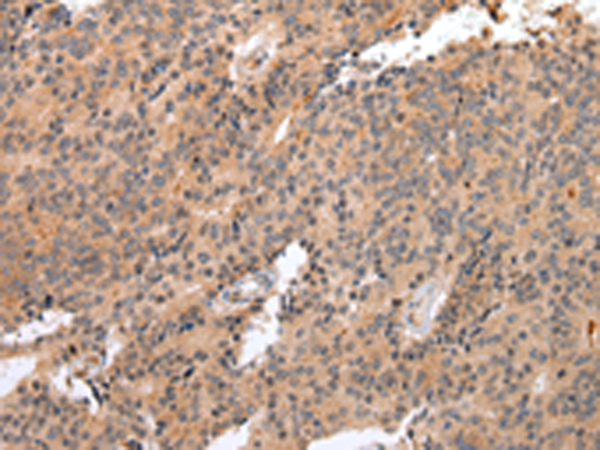
一抗

中文名稱: 兔抗IL18RAP多克隆抗體
英文名稱: Anti-IL18RAP rabbit polyclonal antibody
別 名: ACPL; CD218b; IL-1R7; IL18RB; CDw218b; IL-1R-7; IL-18RAcP; IL-1RAcPL; IL-18Rbeta; IL-18R-beta
儲 存: 冷凍(-20℃)
抗 原: IL18RAP
宿 主: Rabbit
克隆類型: rabbit polyclonl
技術規格
|
Background: |
The protein encoded by this gene is an accessory subunit of the heterodimeric receptor for interleukin 18 (IL18), a proinflammatory cytokine involved in inducing cell-mediated immunity. This protein enhances the IL18-binding activity of the IL18 receptor and plays a role in signaling by IL18. Mutations in this gene are associated with Crohn's disease and inflammatory bowel disease, and susceptibility to celiac disease and leprosy. |
|
Applications: |
ELISA, WB, IHC |
|
Name of antibody: |
IL18RAP |
|
Immunogen: |
Synthetic peptide of human IL18RAP |
|
Full name: |
interleukin 18 receptor accessory protein |
|
Synonyms: |
ACPL; CD218b; IL-1R7; IL18RB; CDw218b; IL-1R-7; IL-18RAcP; IL-1RAcPL; IL-18Rbeta; IL-18R-beta |
|
SwissProt: |
O95256 |
|
ELISA Recommended dilution: |
1000-2000 |
|
IHC positive control: |
Human esophagus cancer |
|
IHC Recommend dilution: |
25-100 |
|
WB Predicted band size: |
68 kDa |
|
WB Positive control: |
Mouse spleen tissue |
|
WB Recommended dilution: |
200-1000 |


 購物車
購物車 幫助
幫助
 021-54845833/15800441009
021-54845833/15800441009